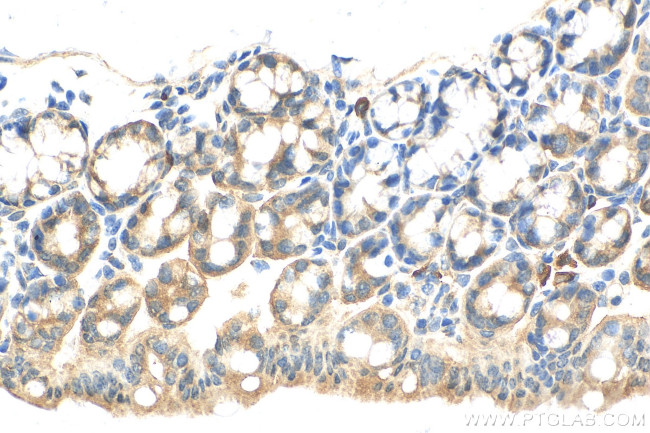
HOOK2 Antibody in Immunohistochemistry (Paraffin) (IHC (P))

Search
Proteintech
HOOK2 Polyclonal Antibody
{{$productOrderCtrl.translations['antibody.pdp.commerceCard.promotion.promotions']}}
{{$productOrderCtrl.translations['antibody.pdp.commerceCard.promotion.viewpromo']}}
{{$productOrderCtrl.translations['antibody.pdp.commerceCard.promotion.promocode']}}: {{promo.promoCode}} {{promo.promoTitle}} {{promo.promoDescription}}. {{$productOrderCtrl.translations['antibody.pdp.commerceCard.promotion.learnmore']}}
产品信息
12458-1-AP
种属反应
宿主/亚型
分类
类型
抗原
偶联物
形式
浓度
规格
纯化类型
保存液
内含物
保存条件
运输条件
产品详细信息
Immunogen sequence: MSVDKAELCG SLLTWLQTFH VPSPCASPQD LSSGLAVAYV LNQIDPSWFN EAWLQGISED PGPNWKLKVS NLKMVLRSLV EYSQDVLAHP VSEEHLPDVS LIGEFSDPAE LGKLLQLVLG CAISCEKKQD HIQRIMTLEE SVQHVVMEAI QELMTKDTPD SLSPETYGNF DSQSRRYYFL SEEAEEGDEL QQRCLDLERQ LMLLSEEKQS LAQENAGLRE RMGRPEGEGT PGLTAKKLLL LQSQLEQLQE ENFRLESGRE DERLRCAELE REVAELQHRN QALTSLAQEA QALKDEMDEL RQSSERAGQL EATLTSCRRR LGELRELRRQ VRQLEERNAG HAERTRQLED
靶标信息
Hook proteins are cytosolic coiled-coil proteins that contain conserved N-terminal domains, which attach to microtubules, and more divergent C-terminal domains, which mediate binding to organelles. The Drosophila Hook protein is a component of the endocytic compartment.
仅用于科研。不用于诊断过程。未经明确授权不得转售。
篇参考文献 (0)
生物信息学
蛋白别名: h-hook2; hHK2; hook homolog 2; Protein Hook homolog 2; unnamed protein product
基因别名: HK2; HOOK2
UniProt ID: (Human) Q96ED9
Entrez Gene ID: (Human) 29911